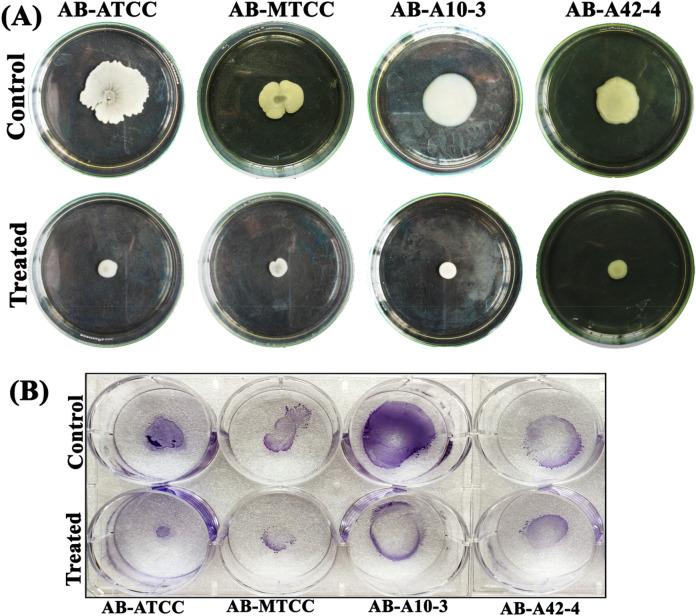
https://cdn.ncbi.nlm.nih.gov/pmc/blobs/522b/7738676/0b7d80a5187d/41598_2020_79128_Fig6_HTML.jpg

肉豆蔻醇的抗生物膜和抗毒力作用增强了鲍曼不动杆菌的抗生素敏感性。
Antibiofilm and antivirulence efficacy of myrtenol enhances the antibiotic susceptibility of Acinetobacter baumannii.
机构信息
Department of Biotechnology, Alagappa University, Karaikudi, Tamil Nadu, 630 003, India.
Department of Food Science and Technology, Pondicherry University, Pondicherry, India.
出版信息
Sci Rep. 2020 Dec 15;10(1):21975. doi: 10.1038/s41598-020-79128-x.
Acinetobacter baumannii (AB) is rising as a human pathogen of critical priority worldwide as it is the leading cause of chronic opportunistic infections in healthcare settings and the condition is ineradicable with antibiotic therapy. AB possesses the ability to form biofilm on abiotic as well as biotic surfaces which plays a major role in its pathogenesis and resistance in clinical settings. Hence, the demand for an alternative therapy to combat the biofilm-associated infections is increasing. The present study explored the antibiofilm potential of myrtenol, a bicyclic monoterpene present in various plants against reference and clinical strains of AB. Myrtenol (200 μg/mL) exhibited a strong antibiofilm activity without exerting any harmful effect on growth and metabolic viability of AB strains. Microscopic analyses confirmed the reduction in the biofilm thickness and surface coverage upon myrtenol treatment. Especially, myrtenol was found to be effective in disrupting the mature biofilms of tested AB strains. Furthermore, myrtenol inhibited the biofilm-associated virulence factors of AB strains such as extracellular polysaccharide, cell surface hydrophobicity, oxidant resistance, swarming and twitching motility. Transcriptional analysis unveiled the suppression of the biofilm-associated genes such as bfmR, csuA/B, bap, ompA, pgaA, pgaC, and katE by myrtenol. Notably, myrtenol improved the susceptibility of AB strains towards conventional antibiotics such as amikacin, ciprofloxacin, gentamicin and trimethoprim. Thus, the present study demonstrates the therapeutic potential of myrtenol against biofilm-associated infections of AB.
鲍曼不动杆菌(AB)作为一种全球性的重要人类病原体正在不断上升,因为它是医疗环境中慢性机会性感染的主要原因,并且用抗生素治疗是无法根除的。AB 具有在非生物和生物表面形成生物膜的能力,这在其发病机制和临床环境中的耐药性中起着主要作用。因此,对抗生物膜相关感染的替代疗法的需求正在增加。本研究探讨了存在于各种植物中的双环单萜 myrtenol 对 AB 的参考和临床菌株的抗生物膜潜力。Myrtenol(200μg/mL)表现出强烈的抗生物膜活性,而对 AB 菌株的生长和代谢活力没有任何有害影响。显微镜分析证实了在用 myrtenol 处理后生物膜厚度和表面覆盖率的降低。特别是,发现 myrtenol 在破坏测试 AB 菌株的成熟生物膜方面非常有效。此外,myrtenol 抑制了 AB 菌株的生物膜相关毒力因子,如胞外多糖、细胞表面疏水性、抗氧化剂抗性、群集和蠕动运动。转录分析揭示了 myrtenol 抑制了生物膜相关基因的表达,如 bfmR、csuA/B、bap、ompA、pgaA、pgaC 和 katE。值得注意的是,myrtenol 提高了 AB 菌株对常规抗生素如阿米卡星、环丙沙星、庆大霉素和甲氧苄啶的敏感性。因此,本研究表明 myrtenol 具有针对 AB 生物膜相关感染的治疗潜力。